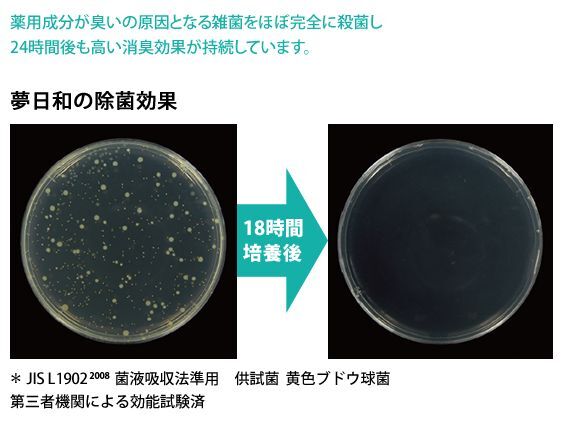
株式会社多磨のプレスリリース画像6

脇の汚れ・角質がポロポロ取れる!新発想ワキガクリームでワキ美人に!~相談実績5000名以上の体臭カウンセラー開発!体臭が気になる夏の必須アイテム!~
株式会社多磨(代表取締役社長:舌間忠利)は4月1日にワキの角質がポロポロ取れる新発想のワキガクリーム「夢日和」(医薬部外品、容量100g 7,970円税込)を発売致しました。(5日分の無料サンプル配布中)開発者でもある舌間は体臭カウンセラーとしても活動し相談件数は7年間で5000件を越えます。
株式会社多磨(代表取締役社長:舌間忠利、所在地:福岡県福岡市中央区赤坂1-14-22-4F)は4月1日にワキの角質がポロポロ取れる新発想のワキガクリーム「夢日和」(医薬部外品、容量100g 7,970円税込)を発売致しました。(5日分の無料サンプル配布中)開発者でもある舌間は体臭カウンセラーとしても活動し相談件数は7年間で5000件を越えます。
夢日和の詳細・サンプル請求はこちら→ http://www.yumebiyori.jp/
開発者は相談件数5000件以上の体臭カウンセラー
初めまして。体臭カウンセラー舌間です。実は私も父からの遺伝でワキガ体質で過去ワキガで悩みを抱えていました。ネット上でワキガであるという事を公表することもとても勇気が必要でした。ですが自分自身がワキガであるからこそワキガの人の悩み、体臭に悩む人の気持ちが分かる。だからこそ「自分の体臭で悩んでいる人を助けたい」という想いから7年前から体臭カウンセラーとして活動をしており、これまでに5000名以上の方の相談や悩みをメールやお電話でお聞きしカウンセリング活動を行なってきました。体臭の問題は本当にデリケートで深刻な悩みです。中には体臭が原因で生きていくのも辛い。と考えている方も多いのが実情なのです。このように体臭の悩みは誰にも相談出来ない悩みと考えている方が多くそんな方々の助けになればと思い、無料相談を行っております。私のパソコンには現在も毎日20~30件もの相談メールが届き、その多くがやはり深刻な悩みを持った方ばかりなのです。今回の夢日和開発もそうですが、これからも様々な活動を通して一人でも多くの方の助けになればと考えております。
開発のキッカケはお客様の声
体臭カウンセラーとしてカウンセリング活動を続ける傍らで、体臭・ワキガの為の商品を開発しております。カウンセリングを行っていますと、体臭に悩む多くの方が、「今すぐなんとかしたい」と考えています。例えば結婚式や親睦会など多くの人が集まる場。学校や職場もそうです。相談者様の声を聞き今すぐなんとかしたいという悩みを解決するべく今回の夢日和を開発致しました。これから暖かくなり季節的にも体臭が気になってきますので、いざという時に使える夢日和を是非体感されてみてください。
古い角質ポロポロ取れる!夢日和でワキ美人に
ワキガ独特のあの匂いは汗とアポクリン汗腺に含まれる毒素やアンモニアと肌の雑菌が混ざることで初めて臭いが発生します。ワキガ体質の方にはこの毒素やアンモニア、黄ばみの原因となるリポフスチンという成分が多くそれらが肌の雑菌と混ざり臭いの原因になります。代表の舌間はその解決策として雑菌を殺菌し雑菌が住み着く古い角質を除去し、更に殺菌することが出来れば臭いの原因を解決し独特の臭いも解消されるのではと考え、何度も試行錯誤を繰り返しました。そして遂に完成したのが夢日和です。この夢日和をワキに塗ることでポロポロと角質が取れ、今までにない感覚実感出来ることでしょう。
参考動画:https://www.youtube.com/watch?v=r7sO8xLqnlI
まずはサンプルから
夢日和は初めてご利用頂く方へは、まずサンプルをお試し頂いております。無料で両脇5回分を配布しておりますので、本当に体臭に悩まれている方はお気軽にお問合せ下さい。
WEBからのオンライン注文、もしくはお電話で受け付けております。
夢日和の詳細・サンプル請求WEBサイト→ http://www.yumebiyori.jp/
TEL 0120-201-305
夢日和の詳細・サンプル請求はこちら→ http://www.yumebiyori.jp/
開発者は相談件数5000件以上の体臭カウンセラー
初めまして。体臭カウンセラー舌間です。実は私も父からの遺伝でワキガ体質で過去ワキガで悩みを抱えていました。ネット上でワキガであるという事を公表することもとても勇気が必要でした。ですが自分自身がワキガであるからこそワキガの人の悩み、体臭に悩む人の気持ちが分かる。だからこそ「自分の体臭で悩んでいる人を助けたい」という想いから7年前から体臭カウンセラーとして活動をしており、これまでに5000名以上の方の相談や悩みをメールやお電話でお聞きしカウンセリング活動を行なってきました。体臭の問題は本当にデリケートで深刻な悩みです。中には体臭が原因で生きていくのも辛い。と考えている方も多いのが実情なのです。このように体臭の悩みは誰にも相談出来ない悩みと考えている方が多くそんな方々の助けになればと思い、無料相談を行っております。私のパソコンには現在も毎日20~30件もの相談メールが届き、その多くがやはり深刻な悩みを持った方ばかりなのです。今回の夢日和開発もそうですが、これからも様々な活動を通して一人でも多くの方の助けになればと考えております。
開発のキッカケはお客様の声
体臭カウンセラーとしてカウンセリング活動を続ける傍らで、体臭・ワキガの為の商品を開発しております。カウンセリングを行っていますと、体臭に悩む多くの方が、「今すぐなんとかしたい」と考えています。例えば結婚式や親睦会など多くの人が集まる場。学校や職場もそうです。相談者様の声を聞き今すぐなんとかしたいという悩みを解決するべく今回の夢日和を開発致しました。これから暖かくなり季節的にも体臭が気になってきますので、いざという時に使える夢日和を是非体感されてみてください。
古い角質ポロポロ取れる!夢日和でワキ美人に
ワキガ独特のあの匂いは汗とアポクリン汗腺に含まれる毒素やアンモニアと肌の雑菌が混ざることで初めて臭いが発生します。ワキガ体質の方にはこの毒素やアンモニア、黄ばみの原因となるリポフスチンという成分が多くそれらが肌の雑菌と混ざり臭いの原因になります。代表の舌間はその解決策として雑菌を殺菌し雑菌が住み着く古い角質を除去し、更に殺菌することが出来れば臭いの原因を解決し独特の臭いも解消されるのではと考え、何度も試行錯誤を繰り返しました。そして遂に完成したのが夢日和です。この夢日和をワキに塗ることでポロポロと角質が取れ、今までにない感覚実感出来ることでしょう。
参考動画:https://www.youtube.com/watch?v=r7sO8xLqnlI
まずはサンプルから
夢日和は初めてご利用頂く方へは、まずサンプルをお試し頂いております。無料で両脇5回分を配布しておりますので、本当に体臭に悩まれている方はお気軽にお問合せ下さい。
WEBからのオンライン注文、もしくはお電話で受け付けております。
夢日和の詳細・サンプル請求WEBサイト→ http://www.yumebiyori.jp/
TEL 0120-201-305
添付画像・資料
企業情報
| 企業名 | 株式会社多磨 |
|---|---|
| 代表者名 | 舌間忠利 |
| 業種 | 医療・健康 |